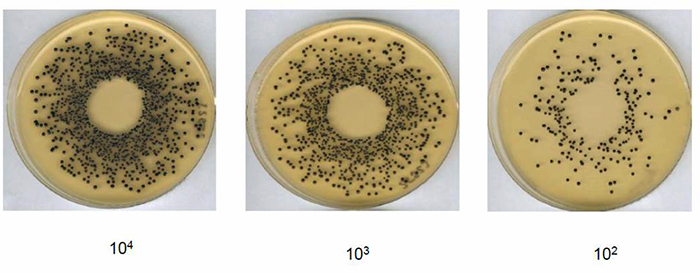
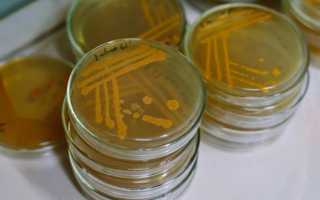

Друзья, продолжаем тему дисбактериоза и сегодня рассмотрим вопрос, какие анализы нужно сдать на дисбактериоз кишечника. Что необходимо сделать, чтобы понять, есть ли у вас проблемы с микрофлорой.
И еще момент интересный, ведь официального заболевания Дисбактериоз, внесенного в международный классификатор болезней, не существует.
Так вышло по причине того, что дисбактериоз вызывается различными факторами, разными другими, предшествующими отклонениями, это следствие разлада в организме.
Нарушение баланса микрофлоры — это всегда проявление каких-то более глубинных факторов.
Если происходит регулярная гибель микроорганизмов, ответственных за нормальное состояние кишечника, то значит есть какие-то неполадки в других органах.
Но и тут может быть замкнутый круг, когда полезные бактерии просто не могут закрепиться на боевых позициях в борьбе с патогенной микрофлорой.
Поэтому препараты с лакто и бифидо культурами необходимо принимать в любом случае.
Анализы на дисбактериоз кишечника
Об этих препаратах я буду говорить в следующих материалах, а сейчас речь пойдет о том, какие анализы нужно сдать, для проверки состояния кишечника на предмет наличия микрофлоры.
Все сдавать нет смысла, можно выбрать какой-то один и обратиться к специалисту за консультацией.
Посев кала на дисбактериоз: это один из основных анализов, позволяющий выяснить, имеется ли дефицит бифидо и лактобактерий.
Также анализ позволяет понять общее количество патогенных бактерий, живущих в кишечнике и подавляющих полезную микрофлору.
Этот диагноз, хоть и простой, но дающий четкую картину происходящего в вашем кишечнике.
Рекомендуется всем, у кого имеются стойкие проявления дисбактериоза — расстройство пищеварения, колиты, проблемы со стулом, рези в кишечнике, вздутие, фурункулы и т. п.
Копрограмма — копрологическое исследование: это более полное исследование содержимого кишечника, позволяет выяснить количественное и поименное наличие разного рода микроорганизмов.
Считаю, что данное исследование необходимо только в сложных случаях, да и то, скорее для медицинских разработок, нежели для пациента.
Если явно видно, что полезной флоры мало, то дальнейшую работу следует строить на поддержание и взращивание лакто и бифидобактерий.
Газожидкостная хроматография фекалий: также сложный анализ, основанный на разделении и дальнейшем анализе составных частей содержимого кишечника. нам, на бытовом уровне это не нужно.
Тем не менее, исследование такое есть, а значит о нем следует упомянуть.
Бактериологическое исследование соскоба: производится соскоб со слизистой оболочки кишечника и изучается детально на предмет наличия той или иной формы бактерий, патогенной и полезной.
Метод позволяет получить более четкое представление о заселении кишечника разными микроорганизмами.
Анализ на наличие индола и скатола в моче: исследование, позволяющее выявить наличие патогенной микрофлоры.
Индол и скатол — токсические вещества, выделяемые вредными микроорганизмами и наличие этих веществ в моче свидетельствует о том, что в организме имеются патогенные бактерии.
Водородный дыхательный тест: сейчас не обязательно сдавать кал на анализ дисбактериоза. Существуют и такие исследования, как дыхательный водородный тест с лактулозой и глюкозой.
Метод также позволяет определить нарушение состава микрофлоры, однако, затем, все-таки может потребоваться более тщательное изучение кишечника.
Степени дисбактериоза
В зависимости от того, насколько разбалансирован состав микрофлоры в кишечнике, выделяют три степени дисбактериоза.
Первая степень: в кишечнике присутствует полезная микрофлора, но ее активность и количество ниже нормы, но не критично.
Как правило, первая степень обнаруживается у подавляющего большинства взрослых людей.
Редкие единицы имеют количественный и качественный состав микрофлоры выше нормы. Просто исключение из правил.
Вторая степень: в анализе присутствуют условно-патогенные микроорганизмы.
Да, лакто и бифидобактерии пока еще могут бороться и подавлять конкурентов, но силы полезной микрофлоры уже на исходе.
Пустующие территории в кишечнике заселяют условно-патогенные микроорганизмы — это те, которые в основном не мешают, но дай им волю, ослабь контроль, и будут они травить организм продуктами своей жизнедеятельности.
Третья степень: критическая, когда в кишечнике уже практически нет следов лакто и бифидокультур, условно-патогенная микрофлора переродилась в патогенную и идет отравление организма.
Про стратегию лечения я буду говорить в следующем материале, а на сегодня все! Я с вами прощаюсь, сейчас буду отвечать на письма с вопросами.
Очередь очень большая и порой переписка — вопрос ответ может задерживаться на долго. Извините, друзья, я по мере сил и времени отвечаю, но всем просто не могу в силу многих причин…
Дисбактериоз – нарушение баланса полезных бактерий в микрофлоре кишечника Исследование кала на дисбактериоз – дисбиоз кишечника – назначается для выявления качественного и количественного изменения в кишечнике, для определения соотношений микроорганизмов, определения выраженности патологического процесса. Оно помогает определить и назначить подходящее лечение: диетическое, пробиотическое, антибактериальное.
Обязательными компонентами этого исследования являются методики количественные и многовекторность исследования (определение всех микроорганизмов микрофлоры), сопоставление результатов исследования с клиническими данными пациента и его возрастом.
Показания к сдаче анализов
Основаниями для сдачи анализа могут является:
- Длительно текущие кишечные расстройства понос, запор, метеоризм.
- Перенесенная кишечная инфекция.
- Гормональная терапия.
- Химеотерапия.
- Антибактериальная терапия.
- Перед операцией.
- При аллергии: бронхиальная астма, атопический дерматит.
Детям в первый год жизни прохождение анализа назначают в следующих случаях:
- Была перенесена внутриутробная инфекция.
- Вскармливание искусственными смесями.
- Плохая переносимость грудного молока.
- Задержки нарастания массы тела или ее резкое снижение.
- Частые респираторные заболевания.
- Стоматит.
- Молочница.
Виды анализов
Методы анализирования на выявление дисбактериоза:
В лаборатории кал подвергается макроскопическому, химическому, и микроскопическому исследованиям. При макроскопическом анализе материал исследуется на цвет, запах, консистенцию, остатки не переваренной пищи. По запаху и цвету можно определить содержание крови, слизи, неправильную переработку белка и жиров поступаемых с пищей.
При химическом исследовании проводится анализ на содержащуюся в фекалиях кровь. Это помогает диагностировать кровопотерю в ЖКТ, полипов, венозное расширение. Исследование микроскопическое определяет наличие в биоматериале мышечных волокон, не переваренной клетчатки.
Показывает наличие патогенных микроорганизмов: сальмонеллы, дизентерийной палочки, синегнойной палочки. В норме эти микроорганизмы не должны присутствовать в теле человека. Их рост и размножение провоцируют кишечные расстройства, и в целом негативно влияют на организм.
Микрохимический анализ основывается на посеве полученного материала на питательную среду. На исследование различных микроорганизмов используется питательная среда определенного состава. Метод позволяет выявить наличие и степенно дисбактериоза.
Подготовка и забор материала для анализа
За четыре дня до сбора анализа пациенту назначается диета, предписывающая воздержание от:
- Алкоголя.
- Острой пищи.
- Антибактериальных препаратов.
- Слабительных средств.
- Вазелина.
- Ректальных свечей.
- Любых клизм.
- Касторового масла.
Правила, которые важно соблюсти при сборе биоматериала:
- Перед взятием биоматериала последнее употребление пищи должно быть не более чем за 80 часов. Испражнение должно быть самопроизвольным. Недопустима стимуляция слабительными препаратами.
- Забор кала происходит в стерильный контейнер прилагающейся к нему ложечкой. Получить стерильный контейнер можно в лаборатории или приобрести в любой аптеке.
- Перед процедурой сбора нужно подмыться простой водой без мыла или гигиенического геля, чтобы в биосырье не попали инородные элементы.
- В первую очередь опорожняется мочевой пузырь. Затем материал собирается в емкость: судно, пеленку, или подгузник. Нужно собрать по не многу с разных частей не касаясь дна. Ни в коем случае вместе с биоматериалом не должна попасть моча, или часть подложки.
- Для анализа необходим не менее 2 грамм фекалий. Это примерно 8 прилагаемых к контейнеру ложечек. Количество материала не должно занимать более 1/3 стаканчика.
- Контейнер должен герметично закрываться – при контакте с воздухом погибают аэробные микроорганизмы. Пациенту следует указать ФИО, год рождения, время сбора.
- Контейнер доставляется в лабораторию не позднее 3-х часов после получения материала. Чем дольше срок передачи, тем сильнее искажается результат диагностики будущего анализа.
- Температура при переноске не должна превышать +2 градусов. Замораживать кал нельзя. Неправильная транспортировка также способна повлиять на исследование.
Результаты и расшифровка
В бланке с результатами анализа есть количественный норматив на каждую проверенную бактерию. Различные показатели у новорожденных, и у детей от одного года и взрослых. Можно самостоятельно свериться с нормой, но консультация врача прояснит картину микрофлоры кишечника более детально. Последующие изменения можно отслеживать самостоятельно.
Нормы для детей до года/ от года и взрослых:
- Патагенные энтеробактерии – 0 / 0
- Гемолизирующая кишечная палочка – 0 / 0
- Кишечная палочка – 300-400 млн/г / 400-1млрд/г
- Кокковые формы в общей сумме микробов – ˂= 25% / ˂= 25%
- Стафилококки – ˂=10 4 / ˂=10 4
- Стафилококк золотистый – 0/0
- Бифидобактерии – 10 10 -10 11 / 10 9 -10 10
- Лактозенегативные энтеробактерии – ˂= 5% / ˂= 5%
- Лактобактерии – 10 6 -10 7 / 10 7 -10 8
- Клостридии – ˂=10 5 / ˂=10 3
- Эубактерии – 10 6 -10 7 / 10 9 -10 10
- Дрожжеподобные грибы Candida – ˂=10 3 / ˂=10 4
- Бактероиды – 10 7 -10 8 / 10 9 -10 10
- Пептострептококки – ˂10 5 / 10 9 -10 10
- Энтерококки – 10 5 -10 7 / 10 5 -10 8
Проблемы с работой желудка, кишечника беспокоят многих людей. Избавиться от них можно после назначения правильного лечения. Определиться с видом терапии поможет анализ на дисбактериоз. Благодаря результатам, лечащий врач узнает о составе микрофлоры кишечника взрослого или ребенка, определит причину дисбаланса, назначит соответствующие методы воздействия.
Какие анализы определяют дисбактериоз
Провести диагностику на наличие дисбактериоза у пациента — непростая задача. Пациентам, которых беспокоят запоры, боли в животе, вздутия, нарушения стула, назначают 2 вида анализов: микробиологический, копроскопию. Первый может проводиться 2 способами:
- Классическая методика. Основан на выращивании колоний бактерий в специальной питательной среде. Оценивать микробиоценоз можно в течение 4–5 дней. Способ дает возможность составить примерную картину. В лаборатории оценят общее количество разновидностей бактерий, находящихся в кале, их соотношение.
- Биохимическое исследование. Результаты анализа получают быстрее. Он, как мазок на пцр, дает точное представление о пристеночной микрофлоре кишок.
Особенности микробиологической диагностики дисбактериоза кишечника
Микробиологический анализ проводится для получения информации о качественном, количественном составе микрофлоры кишечника. В зависимости от метода проведения, врач узнает о том, какие бактерии преобладают в пищеварительном тракте, устанавливает причины заболеваний.
Сложность в проведении диагностики в том, что многие микроорганизмы, живущие в теле человека, являются анаэробными. Для их жизнедеятельности не нужен воздух, а для некоторых он губителен. Для получения наиболее точных показателей, испражнения для проверки нужно брать, соблюдая определенные условия.
Особенность проведения бактериологического анализа — длительность. Получить результаты можно по прошествии определенного срока. Минимум, требуемый для постановки диагноза — 4 дня. Обычно интервал увеличивают до недели. Такой подход позволяет объективно оценить результаты, полученные после выращивания колонии микроорганизмов, сделать выводы о состоянии кишечника.
В ходе проведения анализа выясняется наличие в полости органов ЖКТ:
- Бифидобактерии. Считаются защитниками организма от патогенных воздействий на органы пищеварения.
- Лактобактерии. Помогают усваиваться лактозе, поддерживают кислотность на нормальном уровне.
- Эшерихии. Способствуют избавлению от кислорода.
- Бактероиды. Необходимы для переваривания, всасывания белков, жиров, углеводов.
- Энтерококки. Поддерживают процессы брожения.
- Сапрофитные стафилококки.
- Клостридии. Участвуют в процессе переваривания пищи.
- Кандиды.
- Патогенные стафилококки, энтеробактерии.
Как сдавать анализ
Анализ проводится на основании изучения образцов кала. Для получения результатов необходимо следовать ряду правил:
- отказ от слабительных. Образцы получают естественным путем без использования вспомогательных средств, медикаментов;
- кал собирают в стерильную тару. Крышка баночки плотно закрыта. Приобрести контейнер, чтобы сдать образец, можно в аптеке или лаборатории;
- кал не должен содержать посторонних примесей. Исключить контакт с мочой. Мочевой пузырь опорожняют заранее, проводят гигиенические процедуры, а затем собирают материал для микробиологического исследования;
- для забора кала нельзя использовать унитаз. Рекомендуется применять судно или горшок. Перед дефекацией емкость промывают кипятком, насухо вытирают;
- пробы для анализа берут из разных областей исходного материала. В случае наличия слизи, кровотечений, маленьких прожилок крови, их добавляют в контейнер к образцу для выявлений патологий, лейкоцитов;
- масса материала для анализа не менее 2 грамм;
- пробу для диагностики доставляют в течение 2 часов после забора. При увеличении временного промежутка возможно искажение полученных результатов.
Для объективности диагностики пациент должен заранее, за 2–3 дня до сбора материала отказаться от приема медикаментов, способных повлиять на качественный состав кала. К ним относятся:
- Лекарства от паразитов.
- Таблетки от диареи.
- Слабительные средства.
- Антибиотики.
- Ректальные свечи для лечения любых заболеваний.
- Касторовое, вазелиновое масло.
- Пробиотики.
- Препараты, содержащие барий.
Особые указания для медикаментов, воздействующих на бактериальный фон. От них следует отказать за 12 дней до назначенного анализа. В противном случае они нарушат хрупкую микрофлору, которая не успеет восстановиться до привычного состояния. Результаты диагностики будут неточными.
Перед сдачей биологического материала на исследование проводят подготовку, придерживаются диеты. Ограничения в рацион вводят за 3 дня до сбора кала. Медики рекомендуют отказаться от сырых овощей, фруктов, продуктов красного цвета, содержащих большое количество железа, уменьшить количество потребляемого мяса.
Расшифровка результатов
Расшифровка анализа на дисбактериоз — сложная задача. Сопоставив показатели, можно сделать определенные выводы, назначить лечение. Для этого требуются специальные знания. Пациенту рекомендуется ознакомиться с полученной информацией в домашних условиях для представления о состоянии организма.
В итоговые результаты анализа вносятся такие показатели:
| Бифидобактерии | Норма — 10 8 – 10 10 . Снижение показателей возможно вследствие длительного приема антибиотиков, кишечных инфекций, иммунных заболеваний, нарушения диеты, большого количества жирной пищи. Привести к дисбалансу могут стресс, смена климатической зоны пребывания. |
| Лактобактерии | Норма — 10 6 – 10 8 . Изменения происходят под воздействием инфекций, неправильного питания. Нарушения наблюдаются у людей, страдающих от хронических болезней, поражающих ЖКТ. |
| Эшерихии | Норма — 10 7 – 10 8 . Повлиять на количество бактерий могут инфекции, несбалансированная диета, антибиотики, паразитарные поражения. |
| Бактероиды | Норма — 10 7 – 10 8 . Повышение показателей характерно для людей, потребляющих большое количество жирной пищи, снижение провоцируется приемом курса антибиотиков, кишечными инфекциями. |
| Энтерококки | Норма — 10 5 – 10 8 . Нарушения свидетельствуют об аллергии, проблемах с иммунитетом. Причина дисбаланса может крыться в антибиотиках, неправильном рационе, уменьшении количества кишечной палочки. |
| Стафилококки | Норма — 10 4 . Важно: таких разновидностей, как золотистый, гемолитический, плазмокоагулирующий в кале быть не должно. Присутствие патогенных стафилококков ведет к развитию тяжелых токсических поражений. |
| Клостридии | Норма — 10 5 . Бактерии опасные, но в сбалансированном количестве нужны организму. Увеличение показателя провоцируется излишним употреблением белковой пищи. |
| Пептострептококки | Норма — 10 5 – 10 6 . |
| Кандида | Норма — 10 4 . Изменения провоцируют стресс, антибиотики, ослабление иммунитета. |
| Патогенные энтеробактерии | Наличие бактерий свидетельствует о наличии серьезных заболеваний, нарушений, требующих вмешательства. |
Самостоятельное толкование результатов обследования может быть ошибочно. Заниматься самолечением на основании полученных выводов запрещено. Составить картину состояния микрофлоры кишечника под силу только медику.
Что означает пролиферация в водородном анализе
Пролиферация — термин, которым характеризуется процесс деления, роста клеток. Естественная процедура, происходящая в организме. Не приносит вреда человеку, способствует восстановлению после болезней, травм.
Другое дело — избыточная пролиферация в расшифровке анализе на дисбактериоз. Экспресс тест на основе водорода помогает проанализировать развитие микрофлоры в тонком кишечнике человека. Излишне активный рост определенных видов бактерий свидетельствует о нарушении баланса. Отклонения приводят к развитию дисбактериоза, вызывающего серьезные проблемы со здоровьем, значительное ухудшение самочувствия.
Любой анализ требует внимательного отношения к соблюдению правил забора материалов, проведению оценки полученных результатов. При верном подходе исследование поможет выявить причину многих заболеваний, устранить их симптомы максимально быстро на ранних стадиях.
Анализ кала на дисбактериоз назначается для подтверждения диагноза.
Дисбактериоз (дисбиоз) представляет собой состояние микробного дисбаланса в кишечнике, вызванное воспалительным расстройством в нем.
Подготовка к анализу кала на дисбактериоз
Существуют различные факторы, которые способны вызвать неблагоприятные изменения в составе кишечной микрофлоры:
- прием некоторых лекарств;
- инфекционные болезни разного происхождения;
- неправильное питание;
- наличие болезней органов пищеварения;
- врожденные пороки или послеоперационные нарушения;
- продолжительное психоэмоциональное перенапряжение;
- аллергические заболевания;
- иммунодефицит;
- избыточные физические нагрузки;
- экологические факторы;
- резкая перемена климатогеографических условий.
Состояние дисбаланса микрофлоры не имеет характерных симптомов. Его проявления похожи на клиническую картину многих заболеваний ЖКТ. Изменение качественного и/или количественного состава микрофлоры можно заподозрить при наличии следующих симптомов:
- нарушения стула (как запор, так и жидкий стул);
- метеоризм;
- непереносимость некоторых продуктов;
- аллергия;
- снижение аппетита;
- выраженная слабость;
- сыпь на коже;
- боли в животе;
- тошнота.
Существует немало методик, направленных на обнаружение дисбактериоза, — копрограмма, бактериологическое исследование кала, ПЦР-диагностика, хромато-масс-спектрометрия и биохимическое исследование микробных метаболитов. Анализы на дисбактериоз назначаются врачом в соответствии с состоянием здоровья пациента.
При копрограмме изучение каловых масс пациента с подозрением на дисбактериоз происходит по следующей схеме: изучается полученный результат анализа на дисбактериоз, учитываются цвет каловых масс, консистенция, присутствие или отсутствие в испражнении каких-либо неестественных примесей, например крови, слизи или непереваренных частичек еды.
Метод хроматомасс-спектрометрия выполняется с применением спектрографа. Такое исследование позволяет определить соотношение массы биологического материала к заряду ионов. Полученные результаты могут быть сохранены в информационной базе.
ПЦР-диагностика (полимеразная цепная реакция) представляет собой высокоинформативный метод, помогающий выявить наличие наследственных патологий, острой или хронической инфекции в кишечнике. Возбудителя дисбактериоза определяют по его ДНК-материалу.
Биохимический анализ — это метод исследования метаболитов (летучих жирных кислот), выделяемых микробами в процессе жизнедеятельности. Анализ прост и позволяет получить результат в течение нескольких часов, диагностировать не только дисбактериоз, но и заболевания ЖКТ.
Наиболее распространенным является бактериологическое исследование, которое заключается в том, что в лаборатории исследуют кал на дисбактериоз. Определяют, какие виды микробов населяют кишечник, и их количество.
При исследовании кала на дисбактериоз нужно учитывать присутствие в кишечнике полостной и мукозной микрофлоры. Полостная флора — это микроорганизмы, которые находятся в свободном состоянии в просвете кишечника. Мукозная флора — бактерии, которые зафиксированы на поверхности слизистой оболочки. В каловой массе на дисбактериоз для анализа имеется только полостная флора.
Данный факт означает, что результат анализа даст только частичную картину того, какой биоценоз присутствует в кишечнике. Преимущественная часть микроорганизмов на поверхности слизистой во внимание приниматься не будет.
Процесс подготовки к исследованию начинают заблаговременно до сбора исследуемого материала. Он заключается в соблюдении следующих требований:
В течение 3 дней избегать употребления продуктов питания, содержащих вещества, которые повлияют на достоверность результата:
За две недели исключить применение лекарственных препаратов, которые могут оказывать влияние на кишечную микрофлору:
- слабительные препараты;
- антибиотики;
- противодиарейные препараты;
- противогельминтные средства;
- ректальные свечи с пробиотиками;
- препараты бария и висмута;
- НПВС (нестероидные противовоспалительные препараты);
- касторовое масло;
- вазелиновое масло;
- клизму.
Анализ кала на дисбактериоз — как сдавать
Бактериологическое исследование имеет специфические аспекты, которые необходимо учесть до сдачи анализа. Важно максимально уменьшить контакт каловой массы с воздухом. В кишечной флоре имеются микроорганизмы-анаэробы, существующие без кислорода. При контакте с воздухом они погибают.
Таким образом, содержание анаэробов в организме больше, чем будет обнаружено. Поэтому, выбирая данный метод исследования, нужно максимально точно соблюдать технологию сбора материала для изучения, чтобы получить достоверный результат.
Перед тем как сдают анализ на дисбактериоз, учитывают несколько правил сбора материала:
- нужно провести гигиенические процедуры в области промежности, чтобы исключить попадание в образец посторонних примесей;
- не использовать никакие вспомогательные средства и медицинские препараты, стул должен быть самопроизвольным;
- подготовить тщательно вымытый и высушенный горшок, судно или другое приспособление, унитазом пользоваться не стоит;
- использовать стерильную емкость для кала с плотно прилегающей крышкой (специальные емкости с ложечкой приобретаются в аптеках либо выдаются в лабораториях);
- не допускать попадание жидкости в кал (моча, вода).
Берется несколько фрагментов кала из разных участков, если присутствует кровь или слизь, взять и их образцы. Необходимо не менее 2 г и не более 10 г кала (около 1 ч. л.).
До того как сдавать кал для анализа на дисбактериоз, нужно убедиться, что получится вовремя доставить его в лабораторию. Чем больше интервал между сбором и приемом кала на исследование, тем меньше точность результата, так как преимущественная часть патогенных агентов погибнет. Рекомендуемое время — не более 2 часов.
Сколько дней займет исследование, зависит от того, какой анализ назначен и насколько загружена лаборатория, в современных клиниках это занимает около 1 недели.
Что показывает анализ
Диагностика дисбактериоза основывается на том, что показывает анализ кала на дисбактериоз. Он демонстрирует, какие бактерии содержатся в кишечной микрофлоре, и их количественное соотношение.
- Бифидобактерии. Доля этих микроорганизмов в микрофлоре составляет около 95%. Они отвечают за синтез таких витаминов, как К и В. Участвуют в процессах усвоения кальция, его соединений и витамина D. Способствуют укреплению иммунной системы. Бактерии выводят токсины, стимулируя стенки кишечника.
- Лактобактерии. Кисломолочные бактерии помогают выработке молочной кислоты и необходимы для полноценного функционирования кишечника. Нормальное содержание лактобактерий — 5%.
- Эшхерия коли, или Кишечная палочка. Несмотря на малое содержание, эта бактерия необходима для поддержания микрофлоры ЖКТ. Кишечная палочка ферментирует лактозу, препятствует увеличению численности условно-патогенных микроорганизмов, поддерживает жизнедеятельность бифидобактерий в кишечнике, помогает выработке витаминов группы В, усвоению кальция и железа. Нормальное содержание кишечной палочки — 1%. Колебание показателя говорит о дисбактериозе или наличии паразитов.
- Бактероиды. Анаэробные микроорганизмы, не образующие спор. Бактероиды участвуют в расщеплении желчных кислот, переваривании пищи, процессах липидного обмена. Эти бактерии постепенно населяют организм человека после рождения. Иногда бывают ошибочно отнесены к вредоносным микроэлементам, хотя их роль в пищеварительном тракте до конца не изучена.
- Энтерококки. Грамположительные аэробы, анаэробы и кокки, колонизирующие тонкий и толстый кишечник, участвуют в ферментации углеводов и препятствуют размножению патогенных или условно-патогенных микроорганизмов. Несмотря на то что энтерококки — возбудители болезней, их небольшое количество должно быть в здоровом организме.
- Патогенные микробы. К патогенным бактериям относят сальмонеллу, шигеллу. Проникая в кишечник, эти микроорганизмы провоцируют развитие инфекционных кишечных заболеваний. Даже малое количество этих бактерий становится причиной госпитализации.
- Стафилококки. Эпидермальный стафилококк, аналогично энтерококкам, относится к группе условно-патогенных бактерий, это часть микрофлоры здорового кишечника.
- Золотистый стафилококк относят к микробам внешней среды, малейшее попадание этих микроорганизмов в кишечник способно вызвать расстройство, сопровождаемое болями в области живота, рвотой или поносом.
- Грибки. Дрожжеподобные бактерии грибов рода Candida содержатся в микрофлоре здорового кишечника. Их количество может увеличиваться после приема антибиотиков. Основная задача — поддержание уровня кислотности.
Профилактические обследования по изучению кала, исследования на дисбактериоз могут помочь поддерживать микрофлору в порядке и не допускать развития патологий. Врач оценивает полученные показатели на соответствие нормам согласно возрасту пациента, учитывая предрасполагающие факторы, клинические проявления и анамнез.
Выделяют 4 стадии развития дисбактериоза, разделяют его первичную и вторичную форму.
При первичной форме наблюдается качественный и количественный дисбаланс микрофлоры, что вызывает воспаление слизистых ЖКТ. Вторичная форма — осложнение различных кишечных заболеваний.
- На первой стадии происходит незначительный рост патогенной микрофлоры и уменьшение числа представителей нормальной микрофлоры. Симптомов нет.
- Вторая стадия проявляется в снижении количества лактобактерий и бифидобактерий (облигатная флора) и размножении болезнетворных бактерий. Начинают проявляться первые признаки кишечных нарушений.
- На третьей стадии начинается воспалительное поражение слизистой оболочки кишечника. Симптомы типичны для кишечного расстройства, но принимают хроническую форму.
- Четвертая стадия отличается стремительным развитием острой кишечной инфекции. Отмечаются общая слабость, истощение, анемия. Патогенные микроорганизмы существенно преобладают над полезными, часто собственная микрофлора уже полностью отсутствует.
Лечебную тактику определяют особенности сопутствующего заболевания, дисбактериоз спровоцировавшего, а также особенности преобладающей симптоматики. Основные меры лечения при диагнозе дисбактериоз сводятся к следующему:
- назначение диеты, изменение пациентом образа жизни;
- устранение избыточного роста патогенной микрофлоры в кишечнике;
- обеспечение имплантации полезной для организма микрофлоры;
- разработка мер, ориентированных на повышение иммунитета, что призвано обеспечить нормальную (естественную) микрофлору в кишечнике.
Для чего нужен посев кала
Бактериологический анализ — это основной и чаще всего назначаемый при наличии проблем с ЖКТ. Это исследование позволяет получить информацию о микроорганизмах, обитающих в кишечнике, сосчитать количество, определить их соотношение.
Для получения информации о составе микрофлоры пациентапроводится бактериологический посев — образец помещают на специальную питательную среду.
После получения необходимого роста бактерий специалисты начинают их анализ. Учитывается их плотность, форма, цвет и некоторые биологические особенности. С помощью микроскопического исследования устанавливается вид возбудителя, производится подсчет колоний, определяется степень роста.
Существует четыре степени роста микроорганизмов:
- Скудный рост бактерий.
- До 10 бактерий возбудителя.
- От 10 до 100 колоний.
- Более 100 колоний.
Первые две степени не будут указывать на причину заболевания, однако третья и четвертая степени будут являться критерием для постановки диагноза.
Кроме степени роста, рассчитывается КОЕ (колониеобразующая единица) — специальный показатель, говорящий о количестве микроорганизмов в исследуемом материале. Норма КОЕ для различных бактерий будет разная, так как в кишечнике присутствует своя нормальная микрофлора, выполняющая ряд функций.
После определения возбудителя необходимо также установить его чувствительность к различным антибиотикам. Для этого микроорганизмы помещают в другие среды, содержащие антибактериальные препараты, и по дальнейшему росту колоний судят об эффективности средства. Если роста не наблюдается (это означает гибель микроорганизма), антибиотик считается подходящим для лечения.
Где можно сделать анализ кала на дисбактериоз (адрес и цена)
Для того чтобы сдать анализы или выполнить медицинское обследование, следует обратиться к участковому терапевту, описать свои жалобы и получить направление на исследование в районной поликлинике, так как многие анализы входят в программу ОМС.
При отсутствии такой возможности, нужно обратиться в один из лицензированных медицинских центров, лабораторию или клинику, где можно сдать анализ на дисбактериоз на платной основе. Адреса лабораторий можно узнать у лечащего врача.
Средняя стоимость бактериологического анализа кала (посев на дисбактериоз) составляет — 900 руб., биохимического анализа кала — 2200 руб.
Читайте также: